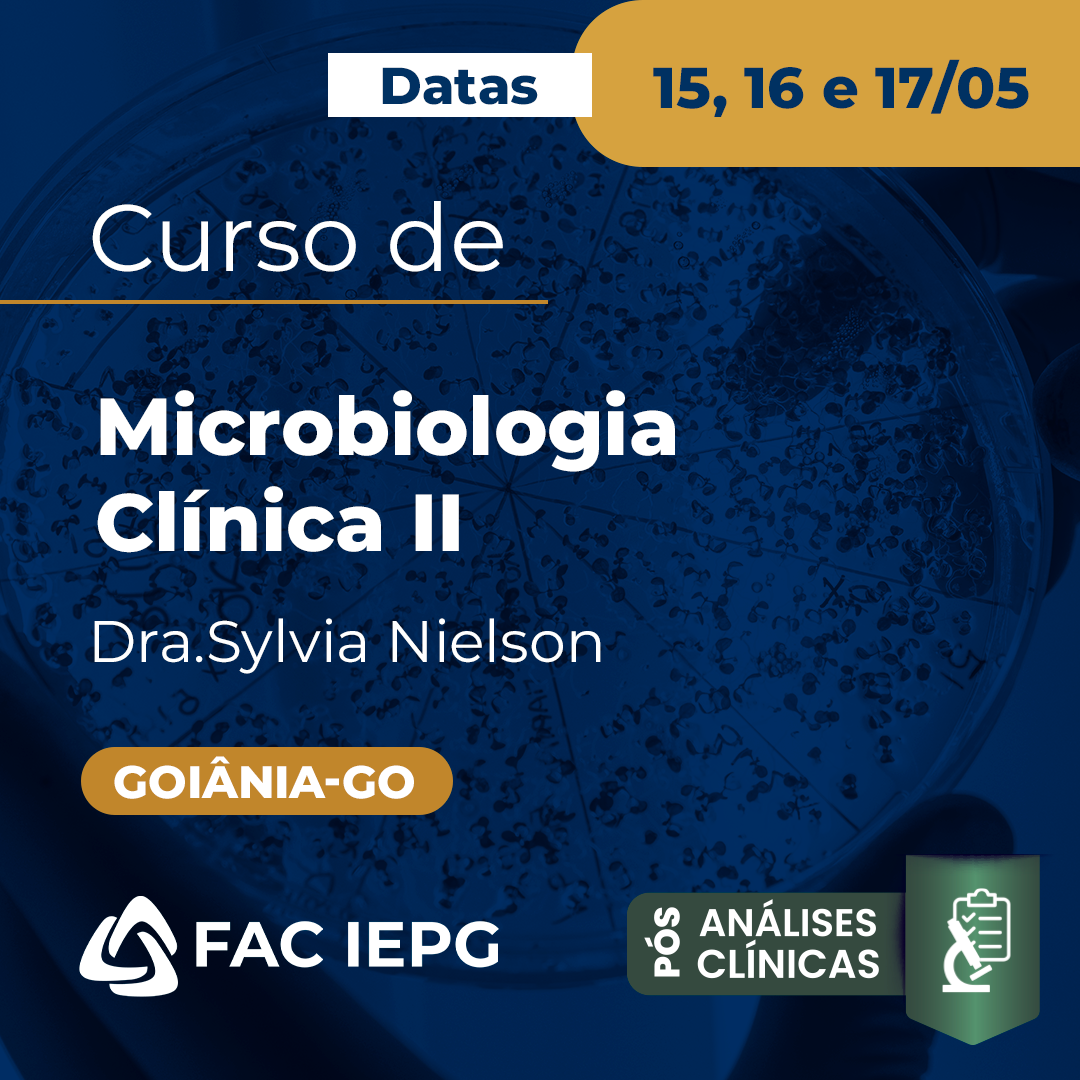

Descrição
O curso de Microbiologia Clínica II é voltado ao aprofundamento dos conhecimentos em diagnóstico microbiológico, sendo essencial para profissionais e estudantes que já possuem base em microbiologia e desejam avançar na identificação dos principais agentes infecciosos. A formação fortalece a compreensão dos métodos laboratoriais utilizados na rotina clínica, contribuindo para resultados mais precisos e confiáveis.
Além disso, o curso capacita o profissional para interpretar corretamente os achados microbiológicos e correlacioná-los com o quadro clínico do paciente, auxiliando na tomada de decisões e no direcionamento terapêutico. Esse aprofundamento é fundamental para garantir diagnósticos mais rápidos, eficazes e alinhados às boas práticas laboratoriais, impactando diretamente na qualidade da assistência em saúde.
Presencial: Goiânia-GO
Data: 15, 16 e 17/05/2026
Carga Horária: 18h